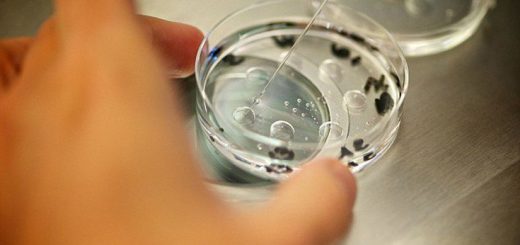

Σαρώνει σε παιδιά και νέους η φυματίωση
Τουλάχιστον 1,8 εκατομμύρια παιδιά και νέοι, ηλικίας δέκα έως 24 ετών, παθαίνουν φυματίωση κάθε χρόνο, σύμφωνα με μια νέα επιστημονική μελέτη, με τη συμμετοχή και ενός Έλληνα επιστήμονα, του επιδημιολόγου δρος Χαράλαμπου Σισμανίδη, του Παγκόσμιου Οργανισμού Υγείας. Είναι...